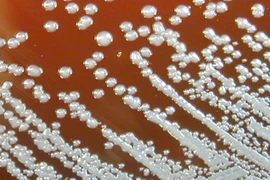
Vi khuẩn B.pseudomallei gây bệnh Whitmore. (Nguồn: CNN)

Vi khuẩn B.pseudomallei gây bệnh Whitmore. (Nguồn: CNN)
Vi khuẩn B.pseudomallei gây bệnh Whitmore. (Nguồn: CNN)
Ngày 20/4, Sở Y tế Đắk Nông cho biết, địa phương vừa ghi nhận một trường hợp đầu tiên mắc Whitmore (do vi khuẩn Burkholderia pseudomallei gây ra, thường gọi là bệnh vi khuẩn ăn thịt người) tại xã Nam Dong (huyện Cư Jút).
Cụ thể, ông T.V.S (65 tuổi, trú tại thôn 15, xã Nam Dong) có khối u vùng đỉnh đầu cách đây hơn 1 năm, từng đi khám nhiều nơi và được chẩn đoán là u mỡ.
Gần đây, ông S thấy đau tức nhiều tại khối u nên được người nhà đưa đi khám và nhập viện tại Bệnh viện Đa khoa Thiện Hạnh (tỉnh Đắk Lắk) vào ngày 14/4/2023. Tại đây, ông S được chẩn đoán viêm xương sọ chẩm, tụ mủ dưới da đầu đỉnh chẩm, đái tháo đường type II.
Ngày 17/4, bệnh nhân được lấy mẫu xét nghiệm và xử lý các triệu chứng nêu trên. Đến ngày 19/4, kết quả xét nghiệm ghi nhận bệnh nhân có kết quả dương tính với vi khuẩn Burkholderia Pseudomallei.
[Người mắc Whitmore thường tiến triển nặng, tỷ lệ tử vong cao]
Hiện bệnh nhân đã tỉnh, tiếp xúc tốt, sức khỏe ổn định và được chuyển sang Bệnh viện Đa khoa Vùng Tây Nguyên (tỉnh Đắk Lắk) tiếp tục theo dõi và điều trị.
Theo ông Huỳnh Thanh Huynh, Phó Giám đốc Sở Y tế Đắk Nông, sau khi ghi nhận trường hợp mắc bệnh Whitmore đầu tiên trên địa bàn, ngành Y tế đã có công văn đề nghị các đơn vị y tế cơ sở tăng cường giám sát chặt chẽ tình hình bệnh này; tổ chức lấy mẫu xét nghiệm các trường hợp nghi ngờ và các đối tượng nguy cơ cao để phát hiện sớm (nếu có) các trường hợp mắc và có phương án điều trị kịp thời.
Cách thức lây nhiễm bệnh Whitmore đa số do người bệnh tiếp xúc trực tiếp với đất và nước bị ô nhiễm, đặc biệt qua các vết trầy xước trên da. Vì thế các chuyên gia khuyến cáo bà con nên đi ủng khi đi xuống ruộng, vũng nước đọng.
Ở những vùng có bệnh, nên cảnh giác vì dấu hiệu mắc bệnh dễ bị nhầm sang bệnh lao và bệnh viêm phổi.
Liên quan đến căn bệnh này, theo thông tin từ Sở Y tế Thanh Hóa, Bệnh viện Nhi Trung ương đã thông báo cho đơn vị này về việc trong tuần đầu tháng 11/2022, Bệnh viện Nhi Trung ương phát hiện hai ca bệnh Whitmore được chuyển đến từ Bệnh viện Nhi tỉnh Thanh Hóa.
Trường hợp thứ nhất là bệnh nhân T.M.N. (sinh năm 2007, ở xã Mai Lâm, thị xã Nghi Sơn). N. được chuyển đến Bệnh viện Nhi Trung ương vào ngày thứ 12 sau khi khởi phát trong tình trạng nặng: phổi tổn thương, suy hô hấp, vẫn còn ban sẩn xuất huyết ở hai bàn tay. Trường hợp thứ 2 là bệnh nhân L.N.Q., sinh năm 2012, ở xã Yên Mỹ, huyện Nông Cống.
Hay trước đó, theo báo cáo của Trung tâm Kiểm soát bệnh tật tỉnh Đắk Lắk, địa phương vừa ghi nhận 1 trường hợp mắc bệnh Whitmore tại huyện Ea Súp.
Cụ thể, ngày 4/6, bệnh nhân N.T.V. (nữ, sinh năm 2013, trú tại thôn Chiềng, xã Ia Lốp, huyện Ea Súp) được người nhà đưa vào khám tại Bệnh viện Đa khoa Vùng Tây Nguyên trong tình trạng tỉnh táo, sốt 39 độ C, tuyến mang tai 2 bên sưng to, cứng, không di động, góc hàm trái có điểm ấn mềm hóa mủ, đau nhiều, há miệng hạn chế, họng đỏ nhẹ loét chợt đầu lưỡi 1 nốt.
Đến ngày 7/6, bệnh nhân sốt cao liên tục, nhiệt độ 41 độ C, áp xe tuyến mang tai 2 bên đã rạch, rỉ mủ máu.
Kết quả xét nghiệm bệnh nhân dương tính với vi khuẩn Burkholderia Pseudomallei với chẩn đoán hậu phẫu áp xe tuyến mang tai 2 bên, nhiễm trùng huyết do vi khuẩn Burkholderia Pseudomallei/TD viêm màng não./.
![[Infographics] Hướng dẫn cách phòng ngừa căn bệnh nguy hiểm Whitmore](https://media.vietnamplus.vn/images/c06a2343df4164d2fe2c753277d10fd8dfa37ea834c4ea4fad1b1f768c864e14b5987c3294d5a0e0c0409cddd81db7fd541e65568c663acbed6a75ba2a62d1d171b0bb527366f33753bab3e655987598/infographicswhitmoreavatar.jpg.webp)